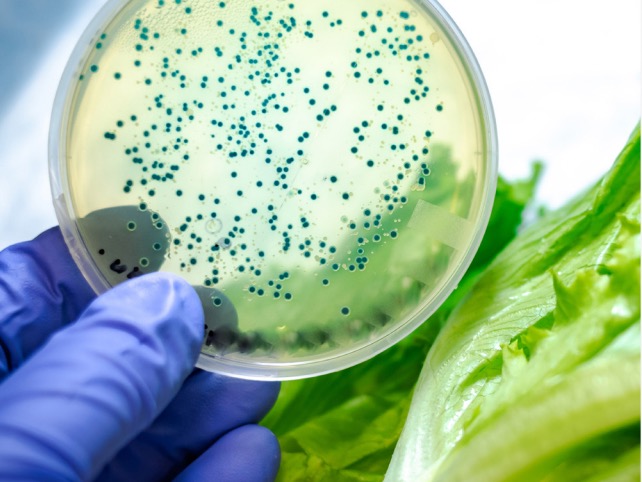
R&D tax incentive backs $2bn of innovation – govt

18th March 2026 Beer / Tax
18th March 2026 Beer / TaxThe government is being urged to slash draught beer taxes in order to improve the viability of hospitality and brewing business and a thriving pub sector.
 12th February 2026 Beer / Tax
12th February 2026 Beer / TaxThe latest move by Australia to freeze draught beer excise should prompt a serious look at how New Zealand treats its own brewers and hospitality businesses, according to industry stakeholders.
 12th February 2026 Government / Tax
12th February 2026 Government / TaxThe government is claiming Investment Boost success, pointing to Inland Revenue survey data, which it says show the policy is tipping investment decisions early, increasing scale, and bringing capital forward.
 7th August 2025 Tax / Transport
7th August 2025 Tax / TransportThe government says it will replace petrol tax with road user charges (RUC) for all of New Zealand’s 3.5 million light vehicles.
 26th March 2025 Regulation / Tax
26th March 2025 Regulation / TaxSubscribe now to enjoy unlimited access to Food Ticker, New Zealand’s new food and beverage industry trade daily. Thank you for visiting Food Ticker. Click here for our subscription packages. We MORE »
 20th November 2024 Environment / Tax
20th November 2024 Environment / TaxDenmark is moving ahead with the world’s first carbon tax on agriculture.
 28th March 2024 Government / Tax
28th March 2024 Government / TaxFinance Minister Nicola Willis’ Budget Policy Statement confirmed the government’s focus on tax reductions, public sector savings, and priority public service priority areas including health, education and law and order.
 22nd March 2024 Politics / Tax
22nd March 2024 Politics / TaxTe Pāti Māori co-leader Rawiri Waititi’s members’ bill to remove GST from kai ran into opposition at its first reading yesterday.
 7th September 2023 Cyclone Gabrielle / Tax
7th September 2023 Cyclone Gabrielle / TaxThe government has confirmed details of the tax changes to the bright-line test for cyclone-damaged properties, with the release of the required legislative amendments.
1st June 2023 Tax
1st June 2023 TaxThe government’s Research and Development Tax Incentive has supported more than $2bn of New Zealand business innovation – an increase of around $1bn in less than nine months.
 12th March 2021 Brewers Association / Tax
12th March 2021 Brewers Association / TaxThe Brewers Association of New Zealand is calling on the Government to half the rate of excise tax paid on kegs.
© 2026 Business Media Network Ltd
Tourism Ticker | Property Ticker
Website by Webstudio